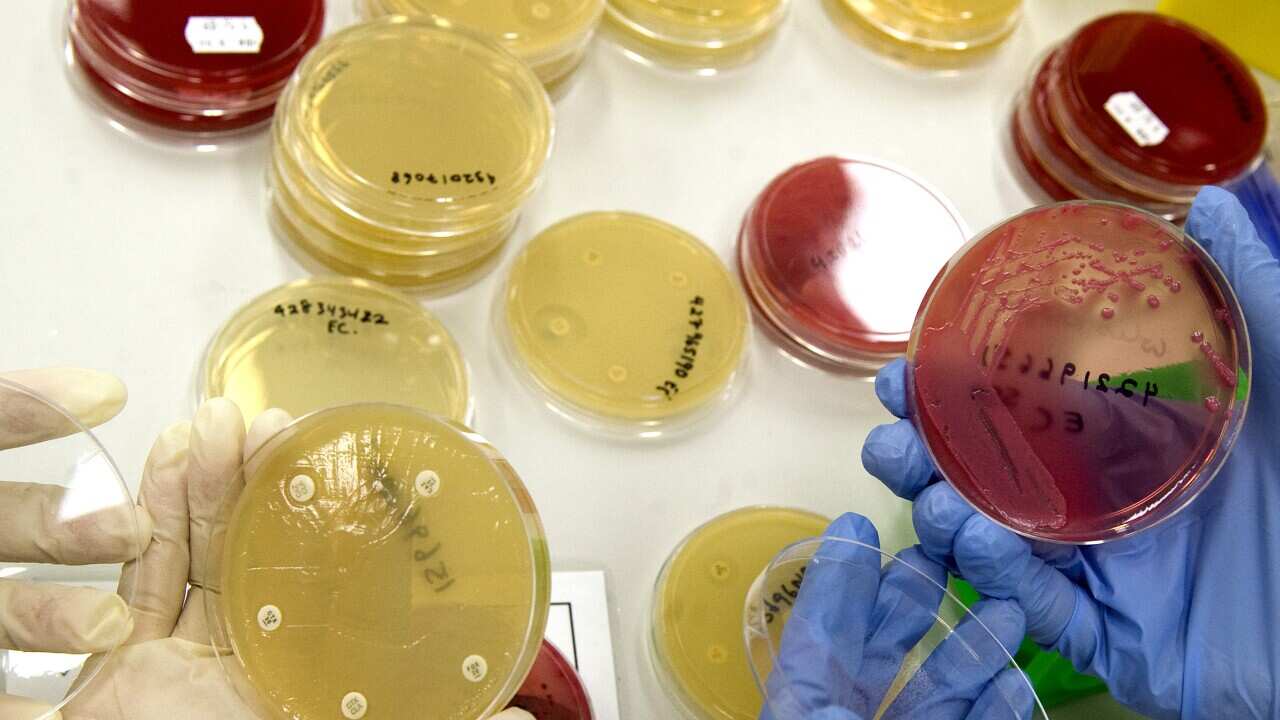
NEW SUPERBUG BRISBANE

超級細菌是指一些對抗生素或其他治療藥物有抗藥性的細菌、病毒、寄生蟲或真菌菌株。
該報告指,澳洲正在目睹一場「無聲大流行疫症」,就是抗菌素抗藥性 (AMR) 的問題。報告指, 由於濫用或過度使用一些用來對抗細菌和其他微生物的藥物,例如是抗生素, 而令這些細菌和微生物產生抗藥性時,這將會令大家回復到抗微生物劑前的時代,並會令一些普通的感染變成是致命的問題,同時,亦令一些手術面臨太大的風險而無法進行。
該份題為《遏制抗菌素抗藥性:一種以技術為動力、以人為本的抗擊「無聲大流行疫症」的方法》的報告,呼籲加強全國協調,並著重簡化新型抗菌素耐藥性解決方案和技術的商業化進程。
CSIRO帶領減低抗菌素耐藥性行動的負責人 摩根( Branwen Morgan) 說, 世界衛生組織最近亦將抗藥性超級細菌列為是人類面對的全球十大公共衛生威脅之一。
摩根表示:『抗菌素抗藥性將會使一些最重要的抗菌藥物失效,破壞現代醫學並使我們容易受到藥物抗藥藥性的感染。』
她又指出:『這個情況每年在全球造成超過 127 萬人死亡,而且這個數字仍然在繼續上升。』
『根據模型顯示,在澳洲, 抗菌素抗藥性每年可能導致 5000 多人死亡。』
她亦表示,該報告指出澳洲在改進預防、檢測、診斷和應對抗藥性感染的方式以及減少 抗菌素抗藥性所帶來的影響方面的主要挑戰和機遇。
澳洲技術科學及工程學院的行政總裁沃克 (Kylie Walker) 表示,澳洲是有潛力成為開發對抗抗菌素抗藥性技術的領導性國家。
沃克女士說:『澳洲擁有大量具創意的對抗抗菌素抗藥性技術解決方案。 我們必須通過將之商業化來支持這些創新科技,以便它們能夠以精簡、可持續和協調的方式應付需求。』
其中一些具體例子,包括一些表面噴霧劑可以在有病原體存在時會改變顏色,以及可以在有害微生物到達水道前進行檢測並破解有關微生物的廁所。
CSIRO 的發言人摩根又表示,現時需要優先考慮的是要做好預防工作,因為這樣對減輕未來超級細菌抗藥性的風險是十分重要。
摩根表示:『這是現時社會迫切需要採取的行動。而我們認為,必須以預防方式來解決這個問題,以免令將來的治療是徹底失敗。』
瀏覽更多最新時事資訊,請登上廣東話節目 Facebook 專頁、MeWe 專頁、Twitter 專頁,或訂閱廣東話節目 Telegram 頻道。
SBS 中文堅守《SBS 行為守則》及《SBS 編採指引》,以繁體中文及簡體中文提供公平、公正、準確的新聞報道及時事資訊。SBS 廣東話及 SBS 普通話電台節目均已為大眾服務超過 40 年。歡迎在每天早上 9 至 11 時透過 SBS Radio 1 收聽廣東話節目及在每天早上 7 至 9 時收聽普通話節目,或透過 SBS Radio App 手機應用程式收聽直播及節目重溫。按此進一步了解 SBS 中文。